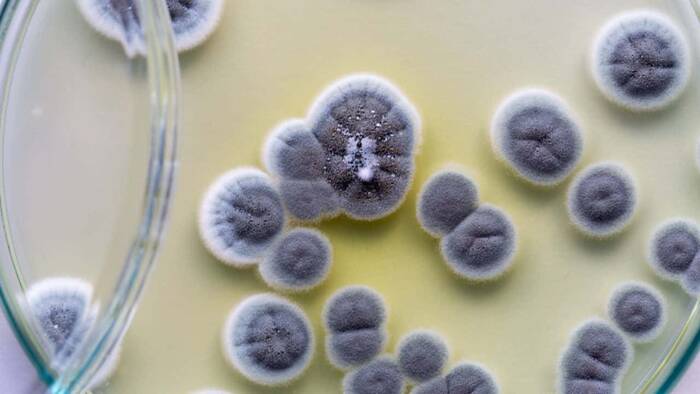
De hongos o fúngicas

La infección, una palabra que seguramente has escuchado infinidades de veces, no solo en esta actualidad de pandemia en la que se habla de los infectados por el SARS-CoV-2 absolutamente todos los días, sino además a lo largo de tu vida porque seguramente en algún momento te has enfermado a causa de una infección, o se te ha infectado una herida y así varios ejemplos más pero ¿qué es una infección?
Pues el termino infección se refiere al proceso mediante el cual un microbio invade un huésped, se multiplica a lo largo de sus tejidos y causa reacciones adversas en ese anfitrión en el que se está alojando. Bacterias, virus, hongos y otros microorganismos son los responsables de realizar estas invasiones infecciosas, que en la mayoría de los casos causan problemas de salud. Pero aún nos queda mucho por decir de las infecciones así que vamos a ello.
Origen

Los pequeños causantes de las infecciones se originaron hace ya unos cuantos años, de hecho las primeras formas de vida comprobadas en la historia de la humanidad fueron las bacterias, virus y microbios, así que ya puedes imaginar que llevan unos añitos merodeando por allí, y naturalmente, han hecho de nosotros (los animales) y de las plantas un terreno que invaden y habitan constantemente.
Así que con la aparición de los humanos hace unos 3 millones de años surgieron las primeras infecciones, pues aparecieron para compartir hábitat con estos microbios o microorganismos, que tienen la capacidad de vivir libremente o invadir a algún huésped como ya hemos mencionado y sobrevivir a las situaciones más adversas.
Algunas de las infecciones de las que se tiene data de su origen son herpes simple, mononucleosis, varicela-zóster, treponematosis y la hepatitis B. Todas encontradas entre los humanos en la época del descubrimiento del fuego, siendo las condiciones hostiles en que vivían en aquella época un factor determinante para que los humanos se infectaran con regularidad.
Otras infecciones importantes y de las más recientes surgieron con la agricultura y la domesticación de los animales, pues esto abrió puerta a las zoonosis, es decir, las enfermedades infecciosas que se transmiten de un animal a un humano o viceversa. Como por ejemplo la rabia, sarampión, toxoplasmosis, brucelosis, teniosis, salmonelosis, gripe, tuberculosis, difteria, la lepra y muchas otras que aún hoy día siguen siendo sumamente masivas alrededor del mundo.
Tipos de infecciones

Y ya que conocemos que son las infecciones, desde que tiempos nos acechan y como han evolucionado, vamos a conocer como se clasifican según el microorganismo que la causa, en ese sentido se dividen en los siguientes cuatro tipos:
Bacterianas

Como bien lo indica su nombre son las infecciones producidas por las bacterias, esos más que diminutos microorganismos unicelulares que se multiplican increíblemente y despiden toxinas sobre los tejidos que la alojan, causando por ello distintas enfermedades.
Curiosamente aunque existe una infinidad de bacterias rondando por nuestro cuerpo, ya sea por dentro, o por los alrededores en los que vivimos, solo un 1% de todas esas especies de bacterias pueden provocar enfermedades en nosotros los humanos, y ese mínimo porcentaje nos ha hecho sufrir a más de uno, imagina donde al menos el 50% de las bacterias nos hicieran enfermar.
Algunas de las especies que forman parte de ese 1% son los estreptococos, los estafilococos y la escherichia coli, bacterias que producen enfermedades como la amigdalitis, la tuberculosis y las infecciones urinarias.
De hongos o fúngicas
Estos microorganismos pueden ser tanto unicelulares como pluricelulares, pertenecen al Reino Fungi, pueden alojarse tanto en vegetales, como en animales, materia en descomposición e inclusive pueden reproducirse en el aire por medio de pequeñas esporas, llegan a ser considerados unos parásitos.
Entre las enfermedades infecciosas más comunes que son producidas por hongos destacan el pie de atleta y la candidiasis vaginal, que se suelen manifestar con sarpullidos y cambios en la piel.
Virales

Microorganismos aún más pequeños que sus predecesores, los hongos y las bacterias. Se caracterizan por su necesidad de invadir otras células vivas y utilizarlas para multiplicarse, pudiendo inclusive dañar o matar la célula en que se está alojando y multiplicando.
Y vaya que para hablar de las enfermedades causadas por los virus podríamos escribir unos cuantos artículos, pues son los causantes del SIDA, ébola, gripe, sarampión, varicela, herpes genital, herpes zoster y muchas más, pero para cerrar con el ejemplo del momento, vale mencionar la Covid-19 producida por el coronavirus llamado SARS-CoV-2.
Parasitarias

Las infecciones parasitarias al igual que las virales son responsables de un montón de enfermedades que afectan a la humanidad en todo el mundo, aunque estas enfermedades tienen su mayor impacto muy especialmente en las regiones tropicales y subtropicales.
El agua, los alimentos, las relaciones sexuales y las picaduras de mosquitos son las 4 armas que utilizan los parásitos para llegar a tu cuerpo y producir entre otras, la enfermedad de Chagas, la Leishmaniasis y la mayor asesina de esta familia, la Malaria.
Prevención

Ese sencillo proceso en el que un microorganismo se aloja sobre un huésped y se multiplica por sus tejidos, es responsable de todas estas enfermedades que hemos mencionados y muchísimas más, algunas pueden ser quizás inofensivas y no pasarán de un resfriado común o una gripe leve, pero hay enfermedades infecciosas letales, de hecho estas son responsables de 16 millones de muertes al año, y algunas destacan en el top 10 de las enfermedades más mortíferas. Todo esto sin profundizar en los números del ya mencionado coronavirus.
Por lo que es importante cuidarse y prevenir al máximo el exponerse a una infección, a continuación algunos consejos de los especialistas para ello:
- Lavarse las manos constantemente, puede sonar fastidioso o cliché, pero vaya que es necesario recordarlo y ponerlo en práctica.
- Lavar y manipular de forma higiénica los alimentos que vayas a consumir.
- Hervir o aplicar otro método de saneamiento al agua.
- Taparse la boca al toser o estornudar con el codo.
- Llevar siempre contigo pañuelos desechables para limpiar tus manos, también gel antibacterial o alochol higienizante si es posible.
- Mantener tus vacunas al día.
Y como última recomendación te damos otra que sonará muy cliché: cuando tengas los síntomas de alguna de estas enfermedades infecciosas (porque es inevitable aún cuidándote que no te contagies alguna vez), acude al médico lo más pronto posible y espera por las instrucciones de este, pues para las infinidades de infecciones y enfermedades que hay, existen infinidades de tratamientos y solo los especialistas pueden determinar cuál necesitas.




